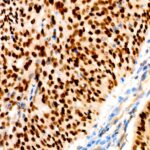

p63 Rabbit mAb (A19652)
$148.00 – $548.00
Abclonal p63 Rabbit mAb (Catalog Number: A19652) encodes a member of the p53 family of transcription factors. The functional domains of p53 family proteins include an N-terminal transactivation domain, a central DNA-binding domain and an oligomerization domain.
- Details & Specifications
- References
| Catalog No. | A19652 |
|---|---|
| Product Name | p63 Rabbit mAb (A19652) |
| Supplier Name | ABclonal, Inc. |
| Brand Name | Abclonal |
| Synonyms | AIS; KET; LMS; NBP; RHS; p40; p51; p63; EEC3; OFC8; p73H; p73L; SHFM4; TP53L; TP73L; p53CP; TP53CP; B(p51A); B(p51B) |
| Gene Name | TP63 |
| Protein Name | TP63 |
| Uniprot/Swissprot ID | Q9H3D4 |
| Gene ID | 8626 |
| Clone | ARC0131 |
| Clonality | Monoclonal |
| Source/Host | Rabbit |
| Reactivity | Human, Mouse |
| Conjugate | Unconjugated |
| Note | Products will be shipped from the warehouse in Massachusetts. Promotion is running from time to time. Welcome to send a request for quote to message@sydlabs.com. |
| Order Offline | Syd Labs, Inc. 4 Avenue E, Hopkinton, MA 01748 USA. Phone: 1-617-401-8149 Fax: 1-617-606-5019 Email: message@sydlabs.com |
Description
A19652: p63 Rabbit mAb
This gene encodes a member of the p53 family of transcription factors. The functional domains of p53 family proteins include an N-terminal transactivation domain, a central DNA-binding domain and an oligomerization domain. Alternative splicing of this gene and the use of alternative promoters results in multiple transcript variants encoding different isoforms that vary in their functional properties. These isoforms function during skin development and maintenance, adult stem/progenitor cell regulation, heart development and premature aging. Some isoforms have been found to protect the germline by eliminating oocytes or testicular germ cells that have suffered DNA damage. Mutations in this gene are associated with ectodermal dysplasia, and cleft lip/palate syndrome 3 (EEC3); split-hand/foot malformation 4 (SHFM4); ankyloblepharon-ectodermal defects-cleft lip/palate; ADULT syndrome (acro-dermato-ungual-lacrimal-tooth); limb-mammary syndrome; Rap-Hodgkin syndrome (RHS); and orofacial cleft 8.
Immunogen Information about p63 Rabbit mAb (A19652)
Immunogen:Recombinant fusion protein containing a sequence corresponding to amino acids 1-203 of human p63 (Q9H3D4).
Sequence:MNFETSRCATLQYCPDPYIQRFVETPAHFSWKESYYRSTMSQSTQTNEFLSPEVFQHIWDFLEQPICSVQPIDLNFVDEPSEDGATNKIEISMDCIRMQDSDLSDPMWPQYTNLGLLNSMDQQIQNGSSSTSPYNTDHAQNSVTAPSPYAQPSSTFDALSPSPAIPSNTDYPGPHSFDVSFQQSSTAKSATWTYSTELKKLYC
Gene ID:8626
Swiss prot:Q9H3D4
Synonyms:AIS; KET; LMS; NBP; RHS; p40; p51; p63; EEC3; OFC8; p73H; p73L; SHFM4; TP53L; TP73L; p53CP; TP53CP; B(p51A); B(p51B)
Calculated MW:77kDa
Observed MW:52-68kDa
Images of p63 Rabbit mAb (A19652)

Western blot analysis of various lysates using p63 Rabbit mAb (A19652) at 1:1000 dilution.
Secondary antibody: HRP Goat Anti-Rabbit IgG (H+L) (AS014) at 1:10000 dilution.
Lysates/proteins: 25μg per lane.
Blocking buffer: 3% nonfat dry milk in TBST.
Detection: ECL Basic Kit (RM00020).
Exposure time: 3min.

Immunohistochemistry analysis of p63 in paraffin-embedded human cervix cancer using p63 Rabbit mAb (A19652) at dilution of 1:100 (40x lens).Perform high pressure antigen retrieval with 10 mM citrate buffer pH 6.0 before commencing with IHC staining protocol.

Immunohistochemistry analysis of p63 in paraffin-embedded human lung squamous carcinoma tissue using p63 Rabbit mAb (A19652) at dilution of 1:100 (40x lens).Perform high pressure antigen retrieval with 10 mM citrate buffer pH 6.0 before commencing with IHC staining protocol.
Please remember our product information: p63 Rabbit mAb (Catalog Number: A19652) Abclonal